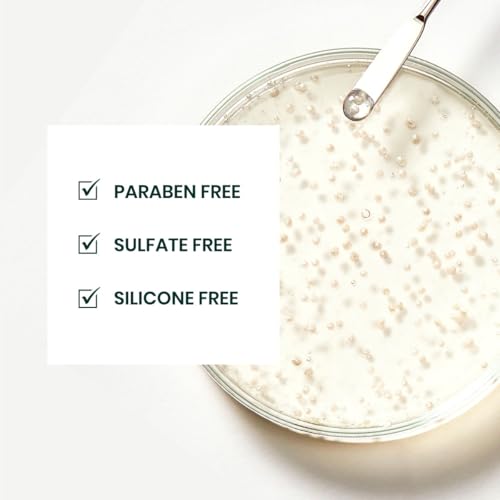

1
/
of
6
MyGiftyy
Rene Furterer TRIPHASIC Thickening Shampoo ? For Thinning Hair ? Improves hair density & strength ? Scalp Nutrition ? Rosemary Oil - For Men & Women - Color Safe
Rene Furterer TRIPHASIC Thickening Shampoo ? For Thinning Hair ? Improves hair density & strength ? Scalp Nutrition ? Rosemary Oil - For Men & Women - Color Safe
Regular price
$116.95 USD
Regular price
$212.99 USD
Sale price
$116.95 USD
Unit price
/
per
Taxes included.
Shipping calculated at checkout.
Couldn't load pickup availability
Share